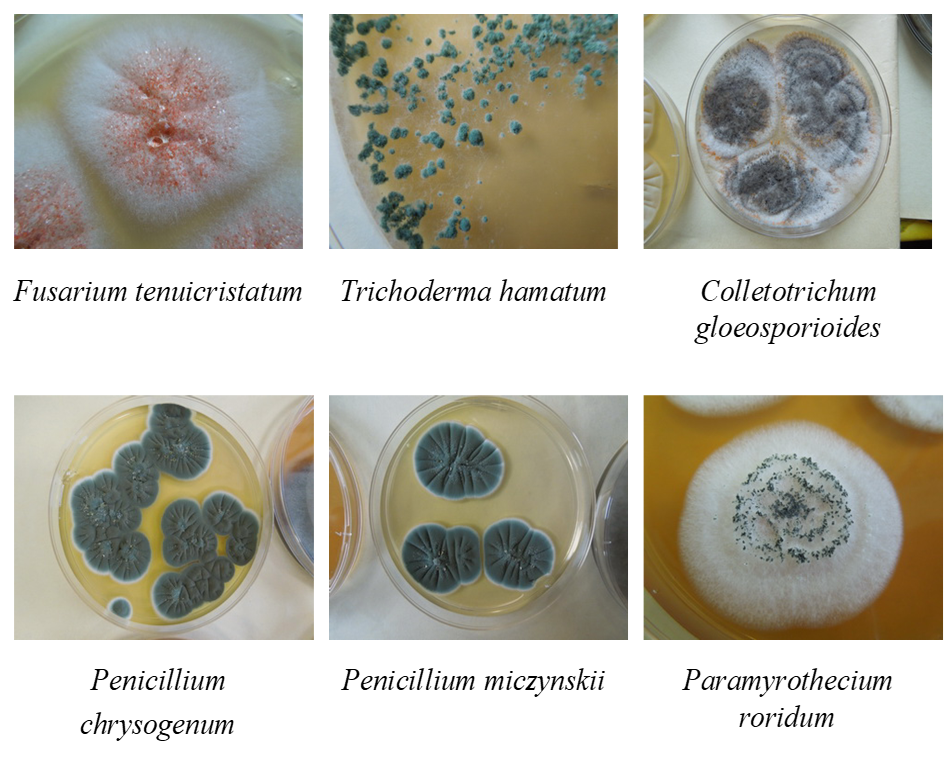

Đánh giá, nghiệm thu kết quả thực hiện nhiệm vụ về nghiên cứu đa dạng sinh học động, thực vật tại các hệ sinh thái rừng đồng bằng và vùng núi Việt Nam
11/04/2024Chiều ngày 10 tháng 4 năm 2024, tại Hà Nội, Trung tâm Nhiệt đới Việt - Nga tổ chức họp Hội đồng KH&CN tư vấn đánh giá kết quả nhiệm vụ thuộc Chương trình Nghiên cứu KH&CN được Ủy ban phối hợp về Trung tâm Nhiệt đới Việt - Nga phê duyệt: “Nghiên cứu đa dạng sinh học động, thực vật tại các hệ sinh thái rừng đồng bằng và vùng núi Việt Nam” giai đoạn 2020-2022, do Viện Sinh thái nhiệt đới là đơn vị chủ trì thực hiện; Đại tá, GS. TS. Nguyễn Đăng Hội và TS. Kuznetsova S.P. là đồng chủ nhiệm. Đây là nhiệm vụ thuộc đề tài “Nghiên cứu tổ chức cấu trúc - chức năng của các hệ sinh thái rừng nhiệt đới phục vụ bảo tồn, phục hồi và sử dụng bền vững”, mã số E-1.2.

Quang cảnh buổi làm việc.
Đồng chí Đại tá, TS. Phạm Duy Nam, Phó Tổng Giám đốc Trung tâm, Chủ tịch Hội đồng chủ trì phiên họp. Tham gia phiên họp, có các thành viên Hội đồng, đại diện cơ quan quản lý khoa học, đơn vị chủ trì và nhóm thực hiện nhiệm vụ.

Đồng chí Nguyễn Đăng Hội báo cáo trước Hội đồng.
Báo cáo tại buổi làm việc, đồng chí Nguyễn Đăng Hội cho biết: Các hệ sinh thái (HST) trên cạn của Việt Nam là những HST đặc thù nhất về đa dạng cảnh quan và tiêu biểu về đa dạng sinh học (ĐDSH) của vùng nhiệt đới, với nhiều loài sinh vật đặc hữu, quý hiếm, có giá trị bảo tồn cao. Tuy nhiên, gần đây, tính ĐDSH và đa dạng quần xã sinh vật rừng tự nhiên đang dần suy giảm. Do đó, các nghiên cứu, kiểm kê và đánh giá hiện trạng đa dạng loài, đa dạng HST là hết sức cần thiết, có ý nghĩa lý luận và thực tiễn. Trước tình hình đó, nhóm nghiên cứu Trung tâm Nhiệt đới Việt - Nga đã tiến hành nghiên cứu tổng hợp về động vật, thành phần và cấu trúc của quần xã thực vật rừng, thành phần của vi sinh vật và nấm, ... Đây là nội dung quan trọng nhằm hiểu rõ hơn về đặc điểm, quy luật hình thành, phát triển các HST đặc biệt này và là nền tảng cho việc xây dựng các giải pháp bảo vệ chúng một cách hiệu quả, tối ưu.

Cán bộ nghiên cứu tại thực địa. (Ảnh: Viện STNĐ).
Trong giai đoạn từ năm 2020 - 2022, nhóm nghiên cứu đã tiến hành khảo sát, nghiên cứu khu hệ động, thực vật tại nhiều địa điểm như Khu Bảo tồn thiên nhiên (KBTTN) Xuân Liên (Thanh Hóa), rừng phòng hộ Tây Giang (Quảng Nam), KBTTN Bình Châu - Phước Bửu (Bà Rịa - Vũng Tàu), rừng phòng hộ Sông Hinh (Phú Yên), rừng đặc dụng Mù Cang Chải (Yên Bái), KBTTN Phù Hoạt (Nghệ An), KBTTN Bát Đại Sơn (Hà Giang), các vườn quốc gia (VQG) Phia Oắc - Phia Đén (Cao Bằng), VQG Phong Nha - Kẻ Bàng (Quảng Bình), VQG Tà Đùng (Đắk Nông), Sông Thanh (Quảng Nam), VQG Vũ Quang (Hà Tĩnh) và các khu vực lân cận Trạm Đầm Báy (Hòn Tre - Khánh Hòa).
Hình ảnh một số loài vi nấm phân lập từ mẫu đất và thảm rụng của KBTTN Bình Châu - Phước Bửu. (Ảnh: Viện STNĐ).
Sau quá trình nghiên cứu, nhóm thực hiện nhiệm vụ đã xác lập mới về thành phần loài, cấu trúc rừng, danh lục các loài động, thực vật địa phương, bao gồm: thú, chim, lưỡng cư - bò sát, động vật thân mềm trên cạn, động vật đất, vi nấm trong đất và thảm rụng. Nghiên cứu cũng đã bổ sung dữ liệu mới về phân bố, sinh học và sinh thái của loài, giống; sửa đổi phân loại một số loài thú, dơi, động vật lưỡng cư - bò sát, bọ cánh cứng và động vật không xương sống ở đất.

Một số loài bò sát ghi nhận tại rừng phòng hộ Sông Hinh. (Ảnh: Viện STNĐ).
Trong khuôn khổ nhiệm vụ và hoạt động hợp tác nghiên cứu, nhóm thực hiện nhiệm vụ đã phát hiện, mô tả và công bố nhiều loài mới cho khoa học; công bố nhiều bài báo khoa học trên các tạp chí chuyên ngành trong và ngoài nước; hoàn thành 01 sách chuyên khảo.


Một số loài mới được công bố. (Ảnh: Viện STNĐ).
Trong báo cáo được trình bày tại buổi bảo vệ, đồng chí Nguyễn Đăng Hội nhấn mạnh: Những kết quả phân tích dữ liệu khoa học từ các chuyến khảo sát, nghiên cứu trên nhiều nhóm sinh vật đã góp phần giải thích, luận giải về nguồn gốc, sự hình thành của hệ động - thực vật địa phương và khu vực. Đồng thời những thông tin này góp phần bổ sung kiến thức mới về các HST và ĐDSH rừng của Việt Nam nói riêng và vùng nhiệt đới nói chung.

Một số loài lưỡng cư và bò sát quý, hiếm được ghi nhận trong thời gian nghiên cứu. (Ảnh: Viện STNĐ).
Tại buổi làm việc, Hội đồng đánh giá nhóm thực hiện nhiệm vụ đã hoàn thành tốt các nội dung nghiên cứu, đáp ứng đầy đủ các mục tiêu đề ra. Kết quả nghiên cứu của nhiệm vụ có ý nghĩa quan trọng, góp phần bổ sung dữ liệu về sinh thái và ĐDSH trong các VQG, KBTTN và rừng phòng hộ của Việt Nam nói riêng và thế giới nói chung. Ý kiến của Hội đồng cũng nhấn mạnh nhiệm vụ có nội dung khoa học phong phú; số liệu báo cáo có độ tin cậy cao; số lượng, khối lượng và chủng loại các sản phẩm của đề tài đạt yêu cầu, trong đó, một số nội dung vượt chỉ tiêu đề ra. Báo cáo tổng hợp thể hiện tốt nội dung và kết quả nghiên cứu, đảm bảo tính logic, khoa học và rõ ràng.

Các uỷ viên phản biện và thành viên Hội đồng nhận xét, đánh giá.
Hội đồng nhất trí nghiệm thu kết quả thực hiện nhiệm vụ trong giai đoạn 2020-2022./.
Tin bài: Phòng TTKHQS
Bài viết liên quan














